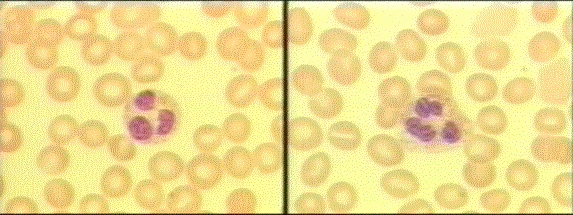
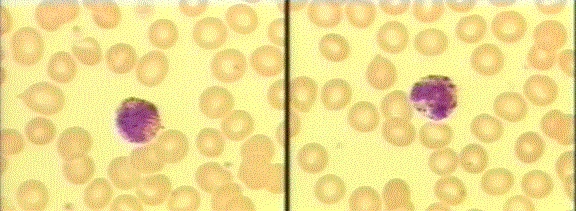
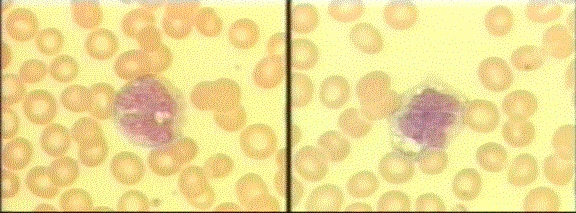

| The white blood cell differential
count determines the number of each type of white blood cell, present in
the blood.
It can be expressed as a percentage (relative numbers of each type of
WBC in relationship to the total WBC) or as an
absolute value (percentage x total WBC). Of these, the absolute value is
much more important than the relative value.
There are five basic white blood cell types:
- Neutrophils
- Eosinophils
- Basophils
- Lymphocytes
- Monocytes
Each WBC cell type has its' own unique features.
Neutrophils (Segmented Neutrophils, Segs, Polymorphonucleocytes,
Polymorphonuclear Neutrophils, Polys, PMNs)
These are the most common of the WBCs and serve as the primary defense
against infection. The typical response to infection or serious injury is
an increased production of neutrophils.
Bands/Stabs
Early in the response to infection, immature forms of neutrophils will
be seen. These are call Stab or Band cells. The presence of
these immature cells is called a "shift to the left" and can be
the earliest sign of a WBC response, even before the WBC becomes elevated.

Eosinophils (Eos)
These cells play a role in allergic disorders and in combating
parasitic infections.
Elevations in eosinophil counts are associated with:
- Allergic reactions
- Parasite infections
- Chronic skin infections
- Some cancers
Decreases in eosinophil counts are associated with:
- Stress
- Steroid exposure
- Anything that may suppress WBC production generally

Basophils (Baso's)
These cells can digest bacteria and other foreign bodies (phagocytosis)
and also have some role in allergic reactions.
Elevations in basophil counts are associated with:
- Some cancers
- Some allergic reactions
- Some infections
- Radiation exposure
Diminished basophil counts are associated with:
- Stress reactions
- Some allergic reactions
- Hyperthyroidism
- Prolonged steroid exposure
Monocytes (Mono's)
These cells respond to inflammation, infection and foreign bodies by
ingesting and digesting the foreign material.
Increased monocyte counts are associated with:
- Recovery from an acute infection
- Viral illness
- Parasitic infections
- Collagen disease
- Some cancers
Decreased monocyte counts are associated with:
- HIV infection
- Rheumatoid arthritis
- Steroid exposure
- Some cancers
Lymphocytes (Lymphs)
These cells play both an immediate and delayed role in response to
infection or inflammation.
Increased numbers of lymphocytes are seen in:
- Most viral infections
- Some bacterial infections
- Some cancers
- Graves' disease
Decreased numbers of lymphocytes are seen in:
- Steroid exposure
- Some cancers
- Immunodeficiency
- Renal failure
- Lupus
|
Normal Values*
| Neutrophils |
#/cubic mm |
% |
|
Men |
3,000-7,000 |
50-60 |
| Women |
1,800-7,700 |
50-60 |
| Pregnancy |
3,800-10,000 |
50-60 |
| Infant |
1,000-8500 |
|
| 8 year old |
1,500-8000 |
|
| Bands/Stabs |
% |
|
Men |
0-3% |
| Women |
0-3% |
| Pregnancy |
0-3% |
| Eosinophils |
#/cubic mm |
% |
|
Men |
50-250 |
1-4 |
| Women |
0-450 |
0-4 |
| Pregnancy |
0-450 |
0-4 |
| Basophils |
#/cubic mm |
% |
|
Men |
25-100 |
0.5-1.0 |
| Women |
25-100 |
0.5-1.0 |
| Pregnancy |
25-100 |
0.5-1.0 |
| Monocytes |
#/cubic mm |
% |
|
Men |
100-600 |
2-6 |
| Women |
0-800 |
0-8 |
| Pregnancy |
0-800 |
0-8 |
| Lymphocytes |
#/cubic mm |
% |
|
Men |
1,000-4,000 |
20-40 |
| Women |
1,000-4,800 |
20-50 |
| Pregnancy |
1,300-5,200 |
20-50 |
| Older Children |
1,000-7,000 |
|
| Infants |
1,000-9,000 |
|
*These are general values taken from a variety of
sources. The actual normal values may vary from lab to lab and from one
type of testing protocol to another.

|